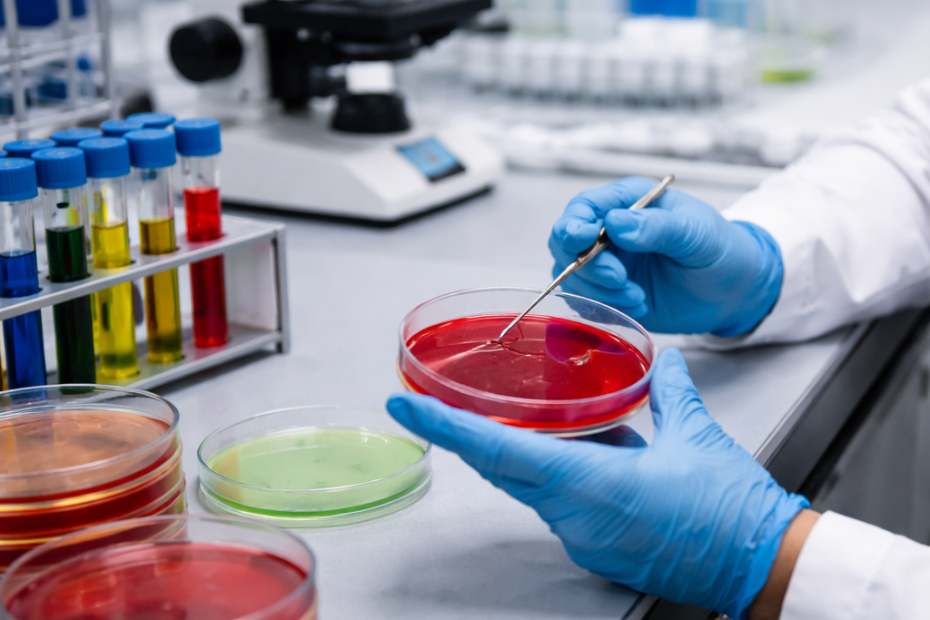

Técnico en Operaciones de Laboratorio
Técnico en Operaciones de Laboratorio FP Grado Medio · Tecnología, Informática e Ingeniería · Acceso: ESO aprobada | Prueba de acceso Empleabilidad Alta Tendencia Creciente Salidas profesionales Técnico de laboratorio|Analista|Auxiliar de laboratorio|Control de calidad|Técnico químico Perfil recomendado Persona responsable, práctica… Leer más »Técnico en Operaciones de Laboratorio